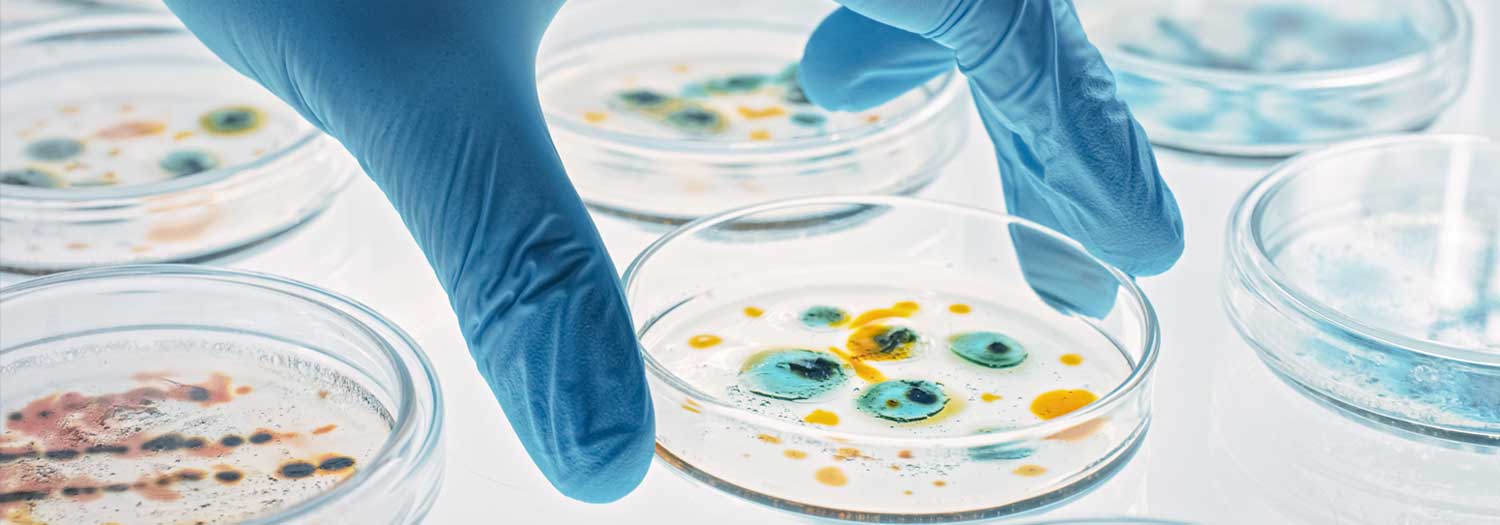

The Institutional Biosafety Committee (IBC) reviews all activities that involve recombinant DNA and/or pathogenic substances and conducts yearly inspections of laboratories where such activities are conducted. Biosafety containment practices protect the faculty, staff, students, volunteers and visitors from exposure to infectious agents, biological toxins, Select Agents/Toxins and rDNA and prevent the release of biohazards into the environment.
IBC review and approval is required prior to using the following biohazardous agents:
- Recombinant DNA (rDNA), as defined by the NIH Guidelines, section 8.2. Some protocols may be exempt under section 1.7 (PDF); however these protocols still require review and approval by the IBC Chair.
- Any microorganism (including but not limited to bacteria, viruses, fungi, rickettsia, protozoa, or parasites) or infectious substance, or naturally occurring, bioengineered or synthesized component of any such microorganism or infectious substance that is capable of causing death, disease or other biological malfunction in a human, an animal, or a plant.
- Select Biological Agents and Toxins, High Consequence Livestock Pathogens and Restricted Plant Pathogens, as per 42 CFR 73, CFR121 and 7 CFR 331.
- Any biological toxin: a toxic material or product of plants, animals, or microorganism (including but not limited to bacteria, viruses, fungi, rickettsia, or protozoa), or infectious substance, or recombinant or synthesized molecule (whatever the origin and method of production).
- Any human blood or body fluid.
- Cell lines, tissues, bodily fluids, feces, or other biologics derived from human or non-human primates.
- The definition also includes projects involving known biohazards that do not appear to fall into one of the above criteria (e.g. prions or cell lines, known to be infected with viruses). If in doubt as to whether a material constitutes a potential biohazard, the NIU Biological Safety Officer should be consulted.
Although federal regulations allow exemptions for some types of rDNA and other agents, the principal investigator (PI) must submit an application for all projects using rDNA and biohazardous materials, agents and toxins so that the IBC is aware of the activities and can verify that they are exempt.